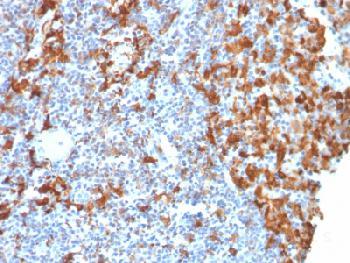

Anti-AIF1 / Iba1 (Microglia Marker) Recombinant Mouse Monoclonal Antibody (Clone:rAIF1/1909)
Figure 1: Formalin-fixed, paraffin-embedded Human Lymph Node stained with AIF1 / Iba1 Mouse Recombinant Monoclonal Antibody (rAIF1/1909).
Roll over image to zoom in
Shipping Info:
For estimated delivery dates, please contact us at [email protected]
Format : | Purified |
Amount : | 100 µg |
Isotype : | Mouse IgG1, kappa |
Purification : | Protein A/G |
Content : | 200µg/ml of recombinant MAb purified by Protein A/G. Prepared in 10mM PBS with 0.05% BSA & 0.05% azide. Also available WITHOUT BSA & azide at 1.0mg/ml. |
Storage condition : | Antibody with azide - store at 2 to 8°C. Antibody without azide - store at -20 to -80°C. Antibody is stable for 24 months. Non-hazardous. |
Gene : | AIF1 |
Gene ID : | 199 |
Uniprot ID : | P55008 |
Alternative Name : | Allograft inflammatory factor 1 (AIF1); balloon angioplasty responsive transcription (BART1); IBA1; Interferon responsive transcript 1; Ionized calcium-binding adapter molecule 1; IRT1; Microglia response factor (MRF1) |
Immunogen Information : | Purified recombinant human AIF1 protein (around aa 1-146) (exact sequence is proprietary) |
AIF1 is a cytoplasmic, calcium-binding protein that is thoµght to play a role in macrophage activation and function. AIF1, containing two EF domains, is induced by cytokines and Interferons. In an unstimulated state, AIF1 colocalizes with actin, and upon stimulation, translocates to lamellipodia. It is also a marker of human microglia and is expressed by macrophages in injured skeletal muscle. The gene encoding AIF1 resides in the tumor necrosis factor (TNF) cluster of genes, located in the region represented by the human major histocompatibility complex (MHC).
Immunohistochemistry (Formalin-fixed) (1-2µg/ml for 30 min at RT)(Staining of formalin-fixed tissues requires heating tissue sections in 10mM Tris with 1mM EDTA, pH 9.0, for 45 min at 95°C followed by cooling at RT for 20 minutes);
For Research Use Only. Not for use in diagnostic/therapeutics procedures.
Subcellular location: | Cytoplasm, Cell projection, Cell projection |
Post transnational modification: | Phosphorylated on serine residues. |
Tissue Specificity: | Detected in T-lymphocytes and peripheral blood mononuclear cells. |
BioGrid: | 106702. 1 interactions. |
There are currently no product reviews
|